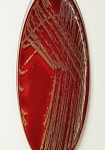

Die Medizin der Zukunft (2011)
0 Playlists

Technische Fortschritte waren für die Medizin seit jeher von größter Bedeutung. Doch spätestens seit Mikrochips und mechanische Elemente immer kleiner werden, ergeben sich völlig neue Wege in der medi- zinischen Forschung: Große Hoffnung setzen Wisseschaftler vor allem in die Kybernetik, die kontrollierte Verbindung aus Mensch und Maschine. In “Die Medizin der Zukunft” dokumentiert DISCOVERY CHANNEL unterschiedliche Forschungsprojekte, die mit innovativen und außer- gewöhnlichen Experimenten kybernetische Techniken weiter entwickelt haben: Vom künstlichen Herzen oder einem bionischen Auge über spezielle Neuro-Implantate, die Querschnittsgelähmten helfen könnten zu gehen, bis hin zur Steuerung von Maschinen durch bloße Gedankenkraft Wissenschaftler geben Aufschluss über viel versprechende Lösungsansätze für die medi- zinische Behandlung von Morgen. Außerdem gewährt der australische Per- formance-Künstler Stelios Arcadiou, kurz Stelarc, in seinem Videotagebuch seltene Einblicke in ein besonders ungewöhnliches Experiment: An seinem Unterarm lässt sich der Cyborg-Fan ein drittes Ohr implantieren, das via Bluetooth die empfangenen Signale direkt ins Internet übertragen soll.
Jetzt herunterladen!
Jetzt herunterladen!
- ~ 45 min.
- Dokumentation
- 0
Trailer
Schließen
Anbieter Auswahl für: Die Medizin der Zukunft
Anbieter Übersicht umschalten

Weitere Details
| IMDb Wertung: | 0 / 10 :: 0 Votes |
| Genre: | Dokumentation |
Empfohlene Einträge für "Die Medizin der Zukunft"
Um einen Kommentar abzugeben melde Dich bitte zuerst an.
Wenn Du noch kein Konto bei uns hast, kannst Du Dich hier registrieren.
Alle Kommentare (0)
Keine Kommentare vorhanden.